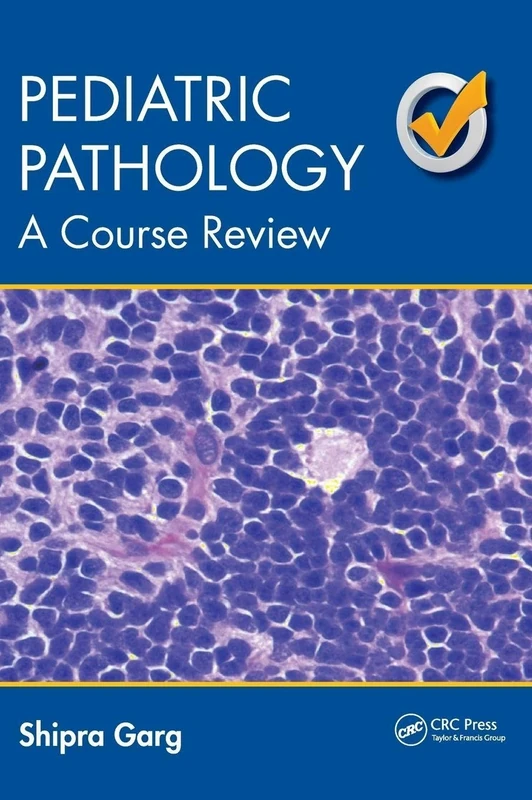
Pediatric Pathology: A Course Review

We can't find the internet
Attempting to reconnect
Something went wrong!
Hang in there while we get back on track

£86.12
CRC Press Pediatric Pathology: A Course Review
9781498723534
Price data checked 3 days ago
We'll watch every seller, every day. One email when your price arrives.
This is the usual price. Wait for it to drop, or tell us your number.
£86 today · usual range £75–£88 · best ever £75
NEW HERE?
Amazon shows you one price. We show you all of them.
Tosheroon watches Amazon prices so you don't have to. Every product on Amazon has a price history — we make it visible. Set the price you'd actually pay, and we'll email you the second it gets there. No app, no account, one email.
WHAT'S ON THIS PAGE
when this has been cheap or pricey
where the price is heading next
all-time high & low, recent range
name your number, we'll email you
Price History & Forecast
Grey patches = out of stock. Cheaper = lower on the chart. Hover for exact prices.
Last 88 days • 88 data points
Price Distribution
Price distribution over 88 days • 4 price levels
Price Analysis
Most common price: £87 (42 days, 47.7%)
Price range: £75 - £88
Price levels: 4 different prices over 88 days
Description
Product Specifications
- Brand
- CRC Press
- Model
- 9781498723534
- Format
- paperback
- ASIN
- 1498723535
- Domain
- Amazon UK
- Release Date
- 01 September 2016
- Listed Since
- 11 March 2016
Barcode
No barcode data available
Similar Products You Might Like
Pediatric Pathology: A Course Review
CRC Press

Concise Paediatrics, Second Edition
CRC Press

Easy Paediatrics
CRC Press

Pediatrics: Pathophysiology, Diagnosis and Treatment
Hayle Medical

Practical Paediatric Procedures (Hodder Arnold Publication)
CRC Press

Great Ormond Street Handbook of Paediatrics
CRC Press

Pediatrics: Care and Treatment
Foster Academics

50 Studies Every Pediatrician Should Know (Fifty Studies Every Doctor Should Know)
Oxford University Press

Diagnosing and Treating Common Problems in Paediatrics: The Essential Evidence-Based Study Guide
CRC Press

Pediatric Hospital Medicine Board Review (MEDICAL SPECIALTY BOARD REVIEW SERIES)
Oxford University Press

Comprehensive Pediatric Hospital Medicine, Second Edition
McGraw-Hill Education

Essential Clinical Skills in Pediatrics: A Practical Guide to History Taking and Clinical Examination
Springer

Pediatrics (Cambridge Pocket Clinicians)
Cambridge University Press

Pediatrics: Medical Care of Children
Hayle Medical

Essential Clinical Skills in Pediatrics: A Practical Guide to History Taking and Clinical Examination
Springer

Pediatric Laboratory Medicine (MEDICAL/DENISTRY)
McGraw-Hill Education

Clinical Guide to Paediatrics
Wiley-Blackwell

Pediatric Clinical Handbook: Diagnosis, Management, and High-Yield Essentials

Challenging Cases in Pediatric Diagnosis: Cases from Pediatric Review, Index of Suspicion and Visual Diagnosis
American Academy of Pediatrics

Year Book of Pediatrics 2013 (Volume 2013) (Year Books, Volume 2013)
Elsevier

The Science of Paediatrics: MRCPCH Mastercourse (MRCPCH Study Guides)
Elsevier

A Paediatric Vade-Mecum, 14Ed
CRC Press

Essential Paediatrics and Child Health
Wiley-Blackwell

Year Book of Pediatrics 2017 (Volume 2016) (Year Books, Volume 2016)
Elsevier